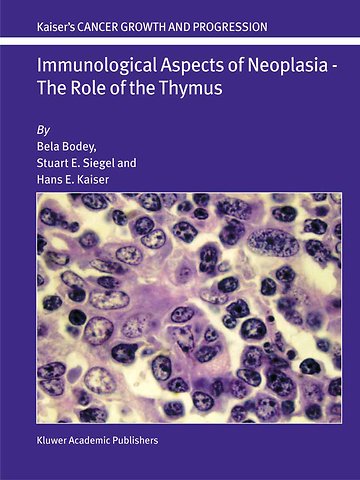
Immunological Aspects of Neoplasia — The Role of the Thymus

Immunological Aspects of Neoplasia — The Role of the Thymus
Samenvatting
Our work began where the greatest classical morphologists left off; their best work was the start of ours. As our work progressed, the rigidity of basic, previous embryological principles was broken down as scientific knowledge advanced. At the same time, the molecular, biological characterization of the cell surface receptor systems progressed enormously with the invention of numerous monoclonal antibodies. Thus, thymology became once again very important because the thymus is the first and central organ of the human immunological system. Then, the question of immuno-neuroendocrine regulation arose and has only been partially answered. Our book seeks to explore what has not been explored. The topic of thymic epithelial cells is a unique one and has never been explored in any previous book as it is explored in this one.
Only a handful of great thymologists remain in the world today, especially after the great loss the medical community suffered with the passing of Dr. Good, the list includes but is not limited to: Dr. Ritter and Dr. Kendall in England, Dr. Savino in Brazil, Dr. Dardenne in France, Dr. von Gaudecker in Germany, a few others in Belgium and Holland, and it is our hope that Dr. Bodey is among them. Nonetheless, a book on the thymus has not been written in the last five years and a book such as this one has never been. This book is based on a 30-year period of research and includes references from a broad range of sources spanning the globe and all sources, even those that were the beginning of thymic research. The book, thus, is uniquely well rounded, more so that previous works.